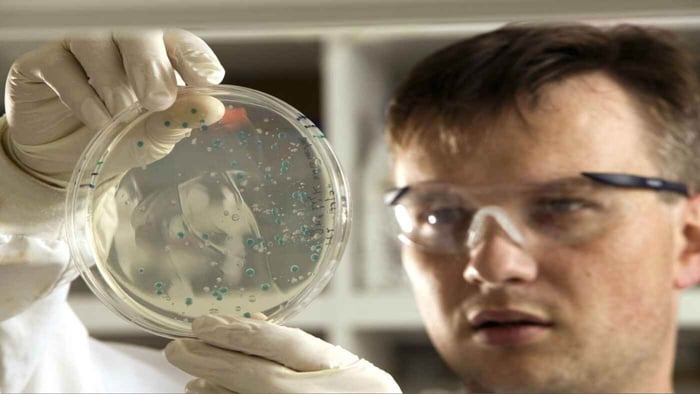
Scientists looking to bioremediation as a way to reverse pollution and regenerate water

- WATER FACTS & TRIVIA
- WATER NEWS
- WATER PHILOSOPHY
- WATER QUOTES
- WATER TRAVEL
- WATER VIEWS
- WATER WELLNESS
- WATER WONDERS
- WATER SOLUTIONS

WAR On Water Part 1 - WATER POLLUTION Legacy Of World War I
 Anna Schoettmer, Devoted Water Journalist
WATER NEWS | WATER VIEWS
Anna Schoettmer, Devoted Water Journalist
WATER NEWS | WATER VIEWS
8 minute read
Table of Contents
The legacy of mustard gas is haunting. Introduced as a weapon during World War I, it claimed nearly ninety-thousand soldiers. This deadly is STILL hangin' in there
Its effects linger, impacting health and the water environment, even today. In this post, we'll explore the ongoing repercussions of this toxic agent. We’ll uncover the lasting scars it left behind and discuss the importance of remembering this dark chapter in H2O history.
 World War 1 Era Gas Mask
World War 1 Era Gas MaskA History of Meager Precautions
Frederick Guthrie did not intend to create mustard gas. In 1860, the British chemist was curious about what would happen if he were to mix ethylene and sulfur dichloride. To his annoyance, the outcome was a set of aggravating rashes and blisters. Another scientist by the name of Albert Niemann re-attempted this chemical mixture within the same year, and to no one’s surprise but his own, he too managed to irritate his skin. Twenty-six years later, Viktor Meyer was the first chemist to synthesize a pure, more toxic version of sulfur mustard without poisoning himself. His assistant was not as lucky. Hans Thacher Clarke was the last main contributor to this gas’ pre-WWI development, his experiments managed to make both the gas and its creation process more efficient. Unfortunately, he did not follow in Meyer’s healthy footsteps of careful precautions and found himself hospitalized for two months with severe burns.
As to why these accredited scientists did not take more safety measures when dealing with a substance that they knew could be deadly, the world will never know. Considering that seventy-five percent of the gas’ main contributors severely hurt themselves with the mixture, it could be assumed that perhaps, just maybe a governmental agency would take a great deal of precautions before introducing it as a chemical weapon. This though, would be greatly overestimating the leaders of the great war era. By the time it was introduced into warfare during the July of 1917, by the German army, there had been little research on the effects of mustard gas. A mistake that will never be forgotten.
A History of Polluted Waters
It is unsurprising due to the nature of gas that sulfur mustard made its way into both surface water and groundwater. Our issues arise not on the surface though, but rather, beneath it. Typically, when mustard gas is introduced into surface water, it is quickly broken down. However, when introduced into the water table, CLICK >> according to the 2019 academic journal Global Security: Health, Science and Policy,
“...mustard gas can persist for a longtime at low water temperatures, and retain blister-forming properties.” As this contaminated Adam's Ale makes its way into drinking wells, it risks human consumption. Consuming sulfur mustard degradation products (primarily the compound thiodiglycol) often leads to chronic respiratory damage, gastrointestinal damage, immune system suppression, chronic skin and eye conditions, and memory loss. Authorities tend to brush off sulfur mustard contamination concerns as the gas is only mildly soluble, meaning that the chances for it to be transferred from the soil to the water table are very slim. This, though, does not mean that it is impossible.
VitaJuwel Grande 5 ELEMENTS Crystal Gem Water Dispenser with Amethyst, Rose Quartz, Chalcedony, Petrified Wood And Ocean Jasper - Reflection, Growth, Foundation

$472.00
Indulge in elegance, healing, and hydration with the VitaJuwel Grande 5 ELEMENTS GemWater Dispenser – where beauty meets well-being in every water drop. Elevate Your...… read more
It is hard to quantify how many individuals have consumed these toxic degradation products as studies regarding mustard gas contamination have been few and far between. Often individuals with thiodiglycol poisoning are not even aware that they have been exposed to these hydrolysis products. This means that despite the slim chance of degradation product poisoning, it is still a very real, plausible threat that affects unknowing communities who have been dis-served with a lack of research on what is in -both- the liquid they drink and their own bodies.
When these studies do occur, they are usually reserved for sites with A HISTORY of large exposure to mustard gas. World War I era Munster, Germany is a good example of this.

According to Wikipedia on a post about an area in Munster "innocuously" called The Muster Training Area
"At the end of the war in 1918 the Gasplatz held about 48,000 tonnes (47,000 long tons; 53,000 short tons) of chemical munitions, several thousand tonnes of chemically-filled captured munitions and 40 tank wagons of unfilled chemicals. These supplies were sunk in the North Sea and the Baltic. During the preparations for this there was a tragic accident on 24 October 1919. A train laden with chemical weapons and munitions exploded. Apart from the Clarkwerk factory and the power station almost the entire facility was destroyed, a total of 42 buildings. Chemical grenades were catapulted for miles around and clouds of poison gas threatened the surrounding villages, some having to be evacuated. Many houses in the surrounding area were badly damaged. In addition to the immediate victims of the explosion there were numerous deaths in the months that followed."As of 2015, data has been recorded regarding thiodiglycol in Munster’s local drinking wells. A fact that would be later published by the area’s newspaper. Tests for thiodiglycol would have never been conducted if it weren’t for a 1919 uncontained explosion that happened at the location’s military chemical warfare test site. Returning BACK TO > Global Security: Health, Science and Policy, this explosion resulted in the destruction of,
“...some storage infrastructure, including buildings and railway tank wagons filled with chemical warfare agents, resulting in the chemicals being released into the environment.” Of course, the main chemical warfare agent discussed in this passage is sulfur mustard - YUCK !!! More studies must be conducted on the water quality of areas with a history of mustard gas exposure.
The fact that Munster did not get comprehensive data on their drinking water being heavily contaminated for ninety-six years is unacceptable. The fact that other sites with similar levels of exposure have still gone untested feels like a set-up for rage bait, especially when thiodiglycol has been found in people who have never even visited areas with this level of contamination.
At the end of the day, it boils down to authorities being scared of the results that they will find. Especially since past decontamination processes have failed; Take Munster’s 1956 vast and expensive attempt to clean up their previous chemical disaster, an attempt that 2015’s study clearly shows to have failed. But, as a society, we no longer need to fear the possible results as they no longer remain ‘un-fixable’. With modern day solutions, we have a chance of restoring our water to a purified state.
A Modern Day Solution
There are two main processes to decontaminate such chemical warfare degradation products. The first step is neutralization, which according to the ACWA’s (Assembled Chemical Weapons Alternatives) website, the process proceeds with the mixing of the heated contaminated water,
“...and a caustic solution, producing hydrolysate. It had a high pH, so acid was added to reduce the pH to neutral, making it suitable for digestion by the microbes used in biotreatment, the next step.”The second is a process of bioremediation, in which microorganisms digest the degradation products into less harmful compounds that can be consumed by humans without adverse effects.
Scientist In The BioRemediation Lab
Scientist In The BioRemediation LabThe only downside to this is that there is no way to completely re-purify the water table. However, through periodical testing of the table at known exposure sites and by setting up treatment processes before it is used as drinking water, we will slowly ‘recycle’ contaminated water– Replenishing our clean water sources all while replenishing the health of affected communities.
Let us know what you think about the war on water - and the environment in general - in the comments and feel free to share about this story.
Watch The Ecological Consequences of Conflicts: World War One (1914-1918), we explore how one of history's deadliest wars left scars not only on humanity but also on the natural world. Hint for our francophile water lovers, lots o' French spoken in this video.
Related Articles

WATER Fluoridation: Fluoride’s IMPACT on Brain HEALTH
8 minute read
In recent years, water fluoridation has come under renewed scrutiny due to evidence that the fluoride...

The Water Legacy Of The Standing Rock Protests
9 minute read
The protests at Standing Rock against the Dakota Access Pipeline (DAPL) were not just about opposing a...

The FLOW of WU WEI and WATER: Embracing Effortless HARMONY
9 minute read
Wu Wei was one of many ancient variations of “go with the flow”. Like water, the idea...
